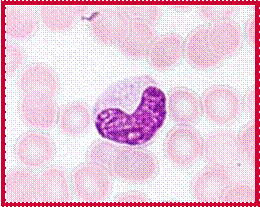

暂无搜索结果
-
1 细胞、组织的适应与损伤,损伤的修复
-
1.1 教学大纲
-
1.2 教学ppt
-
1.3 教学视频
-
1.4 素材资源
-
1.5 课后练习
-
1.6 章节测试
-
2 局部血液循环障碍
-
2.1 教学大纲
-
2.2 教学ppt
-
2.3 教学视频
-
2.4 素材资源
-
2.5 课后练习
-
2.6 章节测试
-
3 炎症
-
3.1 教学大纲
-
3.2 教学ppt
-
3.3 教学视频
-
3.4 素材资源
-
3.5 课后练习
-
3.6 章节测试
-
4 肿瘤
-
4.1 教学大纲
-
4.2 教学ppt
-
4.3 教学视频
-
4.4 素材资源
-
4.5 课后练习
-
4.6 章节测试
-
5 心血管系统疾病
-
5.1 教学大纲
-
5.2 教学ppt
-
5.3 教学视频
-
5.4 素材资源
-
5.5 课后练习
-
5.6 章节测试
-
6 呼吸系统疾病
-
6.1 教学大纲
-
6.2 教学ppt
-
6.3 教学视频
-
6.4 素材资源
-
6.5 课后练习
-
6.6 章节测试
-
7 消化系统疾病
-
7.1 教学大纲
-
7.2 教学ppt
-
7.3 教学视频
-
7.4 素材资源
-
7.5 课后练习
-
7.6 章节测试
-
8 泌尿系统疾病
-
8.1 教学大纲
-
8.2 教学ppt
-
8.3 教学视频
-
8.4 素材资源
-
8.5 课后练习
-
8.6 章节测试
-
9 生殖系统疾病
-
9.1 教学大纲
-
9.2 教学ppt
-
9.3 教学视频
-
9.4 素材资源
-
9.5 课后练习
-
9.6 章节测试
-
10 传染病与寄生虫病
-
10.1 教学大纲
-
10.2 教学ppt
-
10.3 教学视频
-
10.4 素材资源
-
10.5 课后练习
-
10.6 章节测试
-
11 临床病理讨论
-
11.1 临床病理讨论一
-
11.2 临床病理讨论二
-
11.3 临床病理讨论三
-
12 参考资源
-
13 总论实验
-
13.1 教学大纲
-
13.2 教学ppt
-
13.3 教学视频
-
13.4 素材资源
-
13.5 课后练习
-
14 各论实验
-
14.1 教学大纲
-
14.2 教学ppt
-
14.3 教学视频
-
14.4 素材资源
-
14.5 课后练习

选择班级